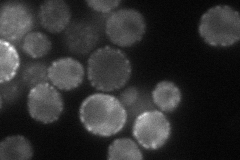
YAL031C
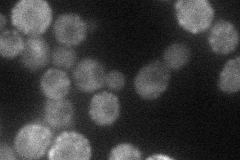
YAL031C
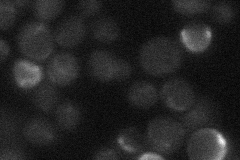
YAL031C
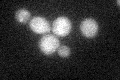
YAL031C
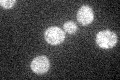
YAL031C

View description
Cytoplasmic Glc7-interacting protein whose overexpression relocalizes Glc7p from the nucleus and prevents chromosome segregation; potential Cdc28p substrate
Localization:
Intensity:
Fold change:
Significance:
-
C’ GFP library in SD

cytosol24.35 -
N' NOP1pr-GFP in SD
cell periphery,punctate60.5095 -
N' TEF2pr-mCherry in SD
punctate32.66 -
N' NATIVEpr-GFP in SD
below threshold17.8086 -
N' TEF2pr-VC and Cyto-VN in SD

cytosol34.7729 -
C’ GFP library in SD+DTT

cytosol26.921.1No -
C’ GFP library in SD+H2O2
cytosol25.771.05No -
C’ GFP library in Starvation Media
cytosol28.31.16No -
C’ GFP library on the background of Pup2-DaMP

cytosol -
C’ GFP library on the background of CCT mutant

cytosol24.91841.02285No
